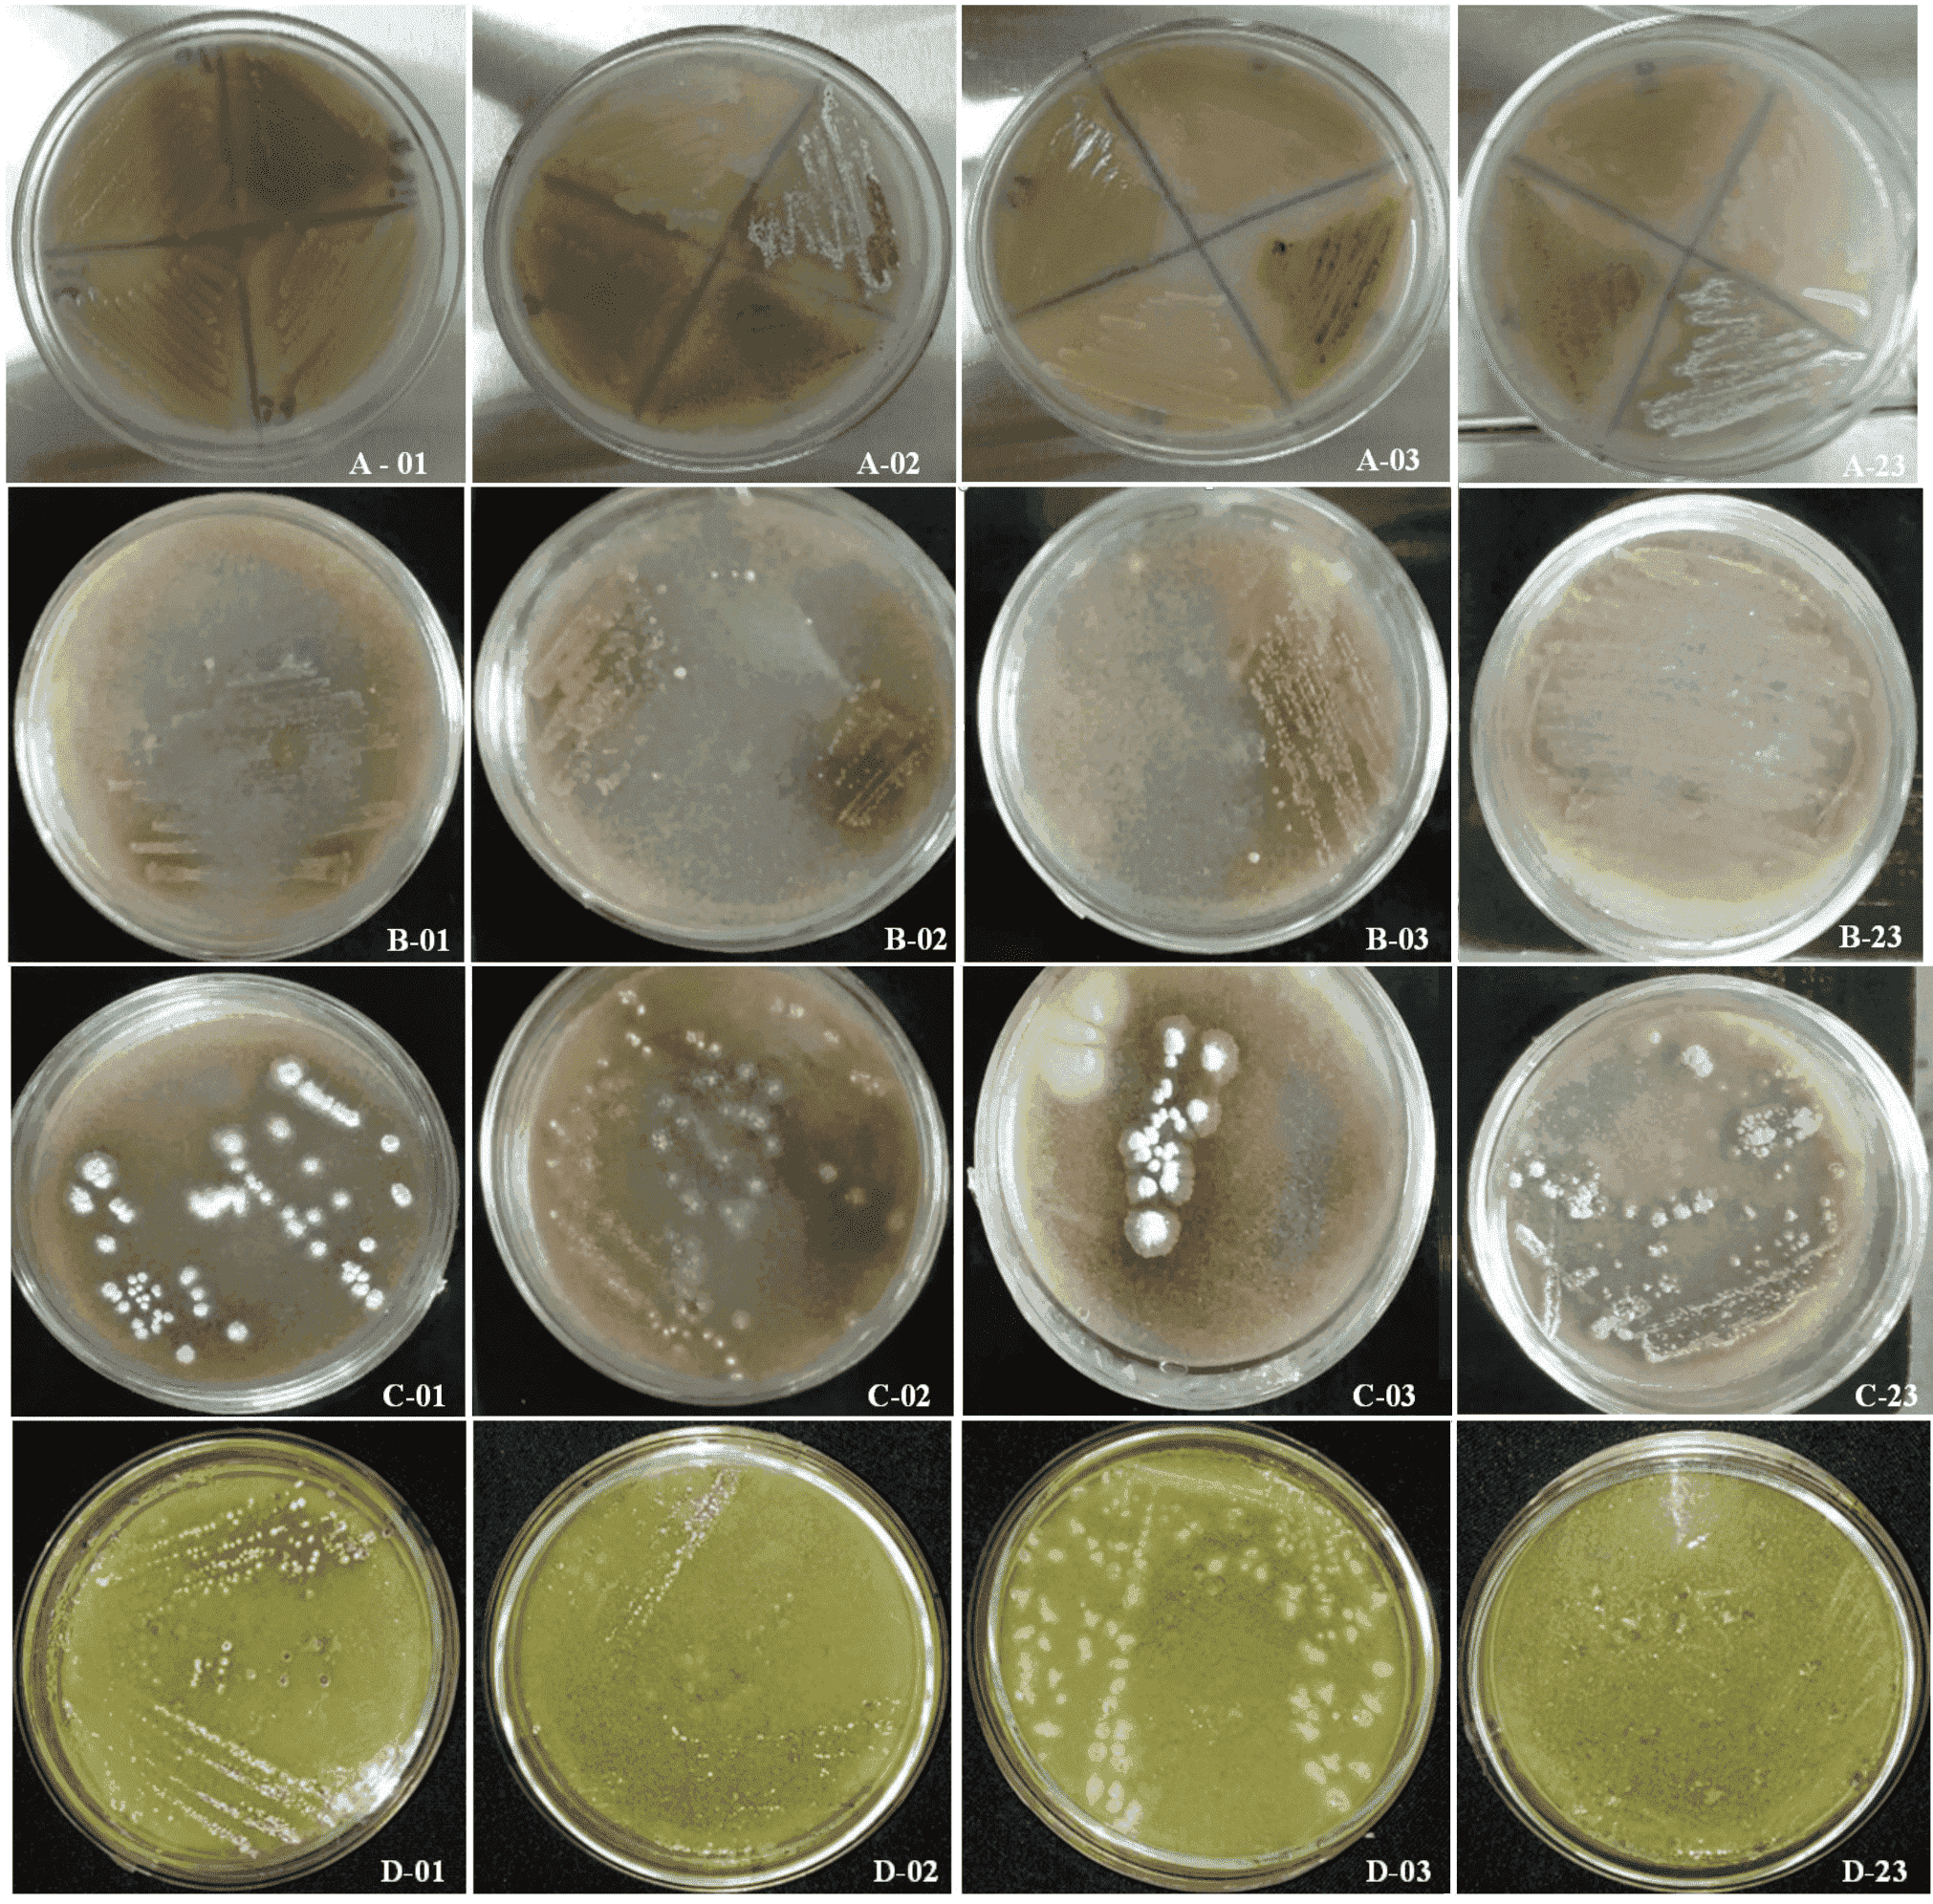
Morphological monitoring of inoculants 01, 02, 03 and 23, performed with ACQ culture medium on days 7, 14, 21 and 30. A. Seven days after inoculation. , B. Fourteen days after inoculation, C. Twenty-one days after inoculation, D.Thirty days after inoculation.

Biotecnologia
Determination of the biodegradability of chitosan utilizing the most probable number technique
Determination of the biodegradability of chitosan utilizing the most probable number technique
Acta Scientiarum. Biological Sciences, vol. 42, 2020
Universidade Estadual de Maringá

Recepción: 13 Abril 2020
Aprobación: 03 Junio 2020
Abstract: The present work aimed to evaluate the degradability of the chitosan polymer by soil microorganisms. This evaluation was accomplished using the Most Probable Number (MPN) method by plating in drops so that soil microorganisms capable of degrading the polymeric material could be quantified. Soil samples diluted in three specific culture media for each type of microorganism were plated – bacteria, fungi and actinobacteria – and they were maintained at 28°C for seven days to determine the growth rate of fungi and actinobacteria, and for 48 hours for the development of bacteria. Significant differences in the MPN of actinobacteria relative to the other groups analyzed were observed. Thus, the method used was effective for determining the degradability of the chitosan biopolymer when observing the development of microorganisms subjected to the replacement of the carbon source by the addition of 2% w v-1 of the chitosan biopolymer to the culture medium. The formation of clear regions around the microbial colonies was a strong indicator of biodegradation.
Keywords: Actinobacteria, carbon source, microorganism.
Introduction
Currently, many studies focus on the analysis of biodegradation of polymers, that is, analysis of the degradation of polymeric materials through the action of living organisms (Fechine, 2013). Unlike the processes of biotechnological degradation of macromolecules of renewable origin, such as cellulose and starch, whose mechanisms are well known, there is still much to be elucidated about the degradation of polymers of fossil origin (Castro, Classen, Austin, Norby, & Schadt, 2010; Cinelli, Coles, & Kirwan, 2014). The replacement of the current polymers, which are harmful to the environment, with biodegradable polymers is desirable. Thus, the determination of methods that allow the assessment of the biodegradability of a polymer and the class of microorganisms capable of degrading them can contribute to studies that guide the disposal of plastic materials.
The rhizosphere, a thin area of soil around the roots that receives carbon exudation from plants, represents a region of intense competition for available carbon and nutrients between surface reactive particles and soil microorganisms (Merino, Nannipieri, & Matus, 2015). Therefore, the microbial activities in the soil are mainly driven by the readily available carbon provided by the flow from roots and by the inflows of the root exudates (Dijkstra, Carrillo, Pendall, & Morgan, 2013). Therefore, the rhizosphere region can be directly affected by the availability of nutrients and the quality of the substrate (Murphy, Writer, McCleskey, & Martin, 2015).
These interactive effects can be of particular relevance in understanding microbial growth and nutrient supply in response to higher atmospheric CO2 concentration and temperature. The fact that the increase in atmospheric CO2 increases photosynthesis and, therefore, root exudation has been well established (Drigo, Kowalchuk, & Van Veen, 2008).
The competition between microorganisms and soil-reactive particles for nutrients and Dissolved Organic Carbon (DOC) is often neglected in the rhizosphere, most likely because of convection and diffusion, phenomena of common occurrence during carbon absorption by microorganisms present in the soil that leads to a decrease in available carbon. According to Jones, Song, Chung, and Masison (2004), another factor to be considered is the microbial absorption of low molecular weight organic substances such as organic acids, amino acids, and polysaccharides, which can corroborate the action of degradation of polymeric materials of renewable origin by microorganisms. It is evident that the participation of microorganisms in the degradation process is of great importance, and this fact instigates researchers to evaluate the biodegradability of polymeric systems formed from polymers of fossil origin. Therefore, more in-depth studies are necessary, such as the biodegradation of polymers of renewable origin, such as chitin and chitosan.
Chitin, a polysaccharide of animal origin, is obtained from residues of the fishing industry. It can be deacetylated to chitosan, a non-toxic, biocompatible and biodegradable biopolymer, or it can be hydrolyzed to N,N´-diacetylquitobiose and N-acetylglycosamine oligomers by aerobic and anaerobic microorganisms (Wieczorek, Hetz, & Kolb, 2014). As chitin is difficult to degrade because of its physicochemical properties, some organisms contain a large repertoire of chitinolytic enzymes for more effective degradation, for example, Actinomycetes and Streptomycetes, which are soil saprophytic bacteria (Saito, Yamanushi, Oka, & Nakano, 1999; Heggset et al., 2012).
The small dimensions of microorganisms and their discontinuous distribution in the soil require that specific methods be used for quantitative assessments of the microbial community (Rocha et al., 2015). Well-known methods for evaluating polymer degradation, such as the respirometric method, where the polymer biodegradability is analyzed and quantified from the CO2 emission of a system (Fechine et al., 2013; Coelho, Almeida, & Vinhas, 2008), already exist. However, these methods require more time and a larger quantity of materials such as reagents and glassware during their execution.
Another method is the quantification of the native population of soil microorganisms capable of degrading the polymeric material using the Most Probable Number (MPN) technique. According to Nicolau (2014), this technique permits the estimation of the number of microorganisms that are present in an original sample through the growth of viable bacteria in a liquid medium. In this technique, similar to plating in a solid medium, a serial dilution of the original sample is made, after which aliquots of these dilutions are added in series to appropriate liquid media.
In the work of Jahnel, Cardoso and Dias (1999), the MPN method was compared with the conventional procedure for counting soil microorganisms in soil samples of different textures. The method of quantification of bacteria and fungi in soil samples via plating by drops provided results similar to those obtained by the traditional procedure. The present study presents an alternative method for evaluating the biodegradability of chitosan biopolymer via the determination of the most probable number of soil microorganisms through analyses of the soil moisture content, experiments of quantification of microorganisms using specific culture media for bacteria, fungi and actinobacteria and replacement of the carbon source by a 2% (w v-1) chitosan solution.
Material and methods
The experiments involved following the steps: preparation of culture media, preparation of soil samples, analysis of soil moisture content and quantification of the microorganisms. The quantification of microorganisms was performed via the preparation of culture media for bacteria, fungi and actinobacteria.
Preparation of culture media
To better comprehend the steps and methods involved in the present work, an acronym was created according to the culture media used. The culture media are shown in Table 1. To determine the number of bacteria, the Nutrient Agar (NA) culture medium was used. It was composed of 500 mL water, 5.0 g agar, 1.5 g meat extract, 5.0 g NaCl and 2.5 g peptone. Two more media were prepared containing one-third the quantities of meat extract and peptone: (i) NAQ medium containing 500 mL water, 5.0 g agar, 0.5 g meat extract, 5.0 g NaCl, 0.83 g peptone and 10 g of chitosan; (ii) NAC medium without chitosan.
The typical culture medium for fungi was prepared by the method of Martin (1950) (MA). It was composed of 500 mL water, 5.0 g agar, 0.50 g KH2PO4, 0.50 g MgSO4.7H2O, 2.5 g peptone, 5.0 g dextrose, and 0.015 g streptomycin. Two more media were prepared: (i) MAQ medium without dextrose and with 2% (w v-1) chitosan; and (ii) MAC medium without dextrose. Both media contained one-third the quantity of peptone that the MA medium contained.
| Microorganism | Culture Medium | Acronym |
| Bacteria | Nutrient Agar Medium | NA |
| Nutrient Agar Medium, w/o carbon source, containing 2% chitosan | NAQ | |
| Nutrient Agar Medium, w/o carbon source | NAC | |
| Fungi | Martin Medium | MA |
| Martim Medium, w/o dextrose, containing 2% quitosan | MAQ | |
| Martin Medium, w/o dextrose | MAC | |
| Actinobacteria | Starch-Casein Medium | AC |
| Starch-Casein Medium, w/o starch, containing 2% chitosan | ACQ | |
| Starch-Casein Medium, w/o starch | ACC |
The typical culture medium for actinobacteria was prepared from the Starch-Casein (SC) culture medium, consisting of 500 mL water, 5.0 g starch, 0.15 g casein, 1.0 g KNO3, 1, 0 g NaCl, 1.0 g KH2PO4, 0.025 g MgSO4, 0.005 g FeSO4, and 9.0 g agar. Two other media were prepared based on this medium: (i) ACQ medium, where the starch was excluded and 2% (w v-1) of chitosan was added; and (ii) ACC medium, where the starch was excluded. Casein was also excluded from both media.
Preparation of soil samples
The soil samples were collected in the vegetable garden of the Universidade Federal dos Vales do Jequitinhonha e Mucuri (UFVJM), JK campus, Diamantina, Minas Gerais, Brazil, and they were diluted in the proportion of 10 g of soil in 90 mL of 0.85% NaCl solution (w v-1), in accordance with the method of Hungria and Araújo (1994), Embrapa (1997). Subsequently, successive dilutions were performed with 1.0 mL aliquots of the suspension and 9.0 mL of 0.85% NaCl (w v-1) up to a factor of 10-3 for fungi and 10-6 for bacteria and actinobacteria.
Analysis of soil moisture content
The samples were sieved (2 mm) and kept refrigerated (± 4°C) until the moment of their analysis. Five samples of 20 g of moist soil were used and placed in a Hafoseries 1600 oven at 180°C. After 24 hours, the dry soil was weighed, and the values that were considered to represent the humidity of each sample were obtained from Equation 1:
(1)where:
U = soil moisture;
PU = wet soil weight;
PS = dry soil weight.
Subsequently, successive dilutions were performed with 1.0 mL aliquots of the suspension and 9.0 mL of 0.85% NaCl (w v-1) up to a factor of 10-3 for fungi, and 10-6 for bacteria and actinobacteria.
Inoculation
The inoculation was accomplished using 15 drops of 0.04 mL of the different dilutions in 0.85% NaCl saline plus soil in 15 mL of the previously autoclaved specific culture media. The dilutions up to the factor 10-3 were added to the culture medium for fungi, and the dilutions up to the factor 10-6 were added to the culture medium for bacteria and actinobacteria, with eight repetitions for each dilution. After inoculation, the plates were kept at 28°C for seven days to determine the growth of fungi and actinobacteria, and they were maintained for 48 hours for bacteria. Readings were made in Petri dishes for the quantification of the microorganisms, qualifying the results as “with development” (positive) or “no development” (negative). The preparation of the samples was accomplished in a laminar flow environment. The inoculation was performed in a solid medium in the form of streaks, using a properly flamed platinum loop. Microscope slides, previously sterilized, were introduced perpendicularly to the medium with the aid of sterile forceps. The plates were protected with parafilm and incubated in a B.O.D. (28 ± 2°C) for 30 days.
Quantification of microorganisms
The quantification of microorganisms was achieved by determining the most probable number (MPN) using the drop plating method described by Jahnel et al. (1999). The calculations for obtaining the final values of the MPN reading followed guidelines cited by Schinner, Öhlinger, Kandeler, and Margesin (1995), according to the following calculations:
The percentage of humidity was obtained using Equation 2:
(2)where:
%U = percentage of soil moisture;
U = soil moisture;
CF = the correction factor was calculated from the Equation 3.
(3)where:
CF= correction factor;
%U= percentage of moisture in the soil;
The final value for fungi was obtained using Equation 4:
(4)where:
LF= value of the final reading for fungi;
MPN= mean of the most probable numbers of the two repetitions of the samples;
CF= correction factor.
The final reading for the bacteria was obtained using Equation 5:
(5)where:
LB= final reading for the bacteria;
MPN= mean of the most probable numbers from the two repetitions for the samples;
CF= correction factor.
Results and discussion
Biodegradability tests were carried out on soil using the Most Probable Number (MPN) technique to understand the degradability of the chitosan polymer in relation to the availability of the carbon source. Therefore, the growth of each group of microorganisms (bacteria, fungi and actinobacteria) was observed in the different culture media prepared.
Culture medium for bacteria
The following culture media were used to verify the efficiency of the MPN technique for bacteria: nutrient agar (NA), culture medium with reduced carbon source and a 2% (m v-1) filmogenic chitosan solution (NAQ), and culture medium without a carbon source (NAC). For the group of bacteria, there is a greater tendency for degradation of the chitosan biopolymer than for the other groups analyzed (Figure 1).
As shown in Figure 1, there is a greater tendency for the development of bacteria in the plates where the inoculation was performed in a complete culture medium, that is, in the nutrient agar (NA) culture medium. There were no statistically significant differences between the NAQ and NAC culture media.
Culture media for fungi
Three culture media were used for the analysis of the efficiency of the MPN technique for fungi: Martin's medium (MA); Martin’s medium without dextrose and with the addition of a filmogenic solution of 2% (w v-1) chitosan (MAQ) and Martin’s medium without dextrose (MAC). As is shown in Figure 2, no significant differences between the MAQ and MAC culture media regarding the MPN for the group of fungi were found. Therefore, there were no changes in growth for fungi in the soil samples used. However, there was a considerable increase in the growth of microorganisms in the culture medium without dextrose.


A similar result was observed by Sawaguchi et al. (2015) in his experiment using sandy soil, where the degradation of chitosan was not observed, and the numbers of fungi and bacteria did not change significantly during 11 days of incubation of the soil regardless of the addition of chitosan. However, when the same experiment was analyzed using silty soil, degraded chitosan was observed. It increased about 8 to 10 times during the 11 days of incubation with chitosan, as was demonstrated by the significant increase in the number of bacteria and fungi.
Culture medium for actinobacteria
For the analysis of the effectiveness of the MPN technique, the assay was performed using the starch-casein culture medium (AC), as well as this medium with a reduction in the quantity of the carbon source (ACC). However, for the culture medium containing the filmogenic solution of 2% (m v-1) chitosan biopolymer (ACQ), there was an increase in the development of microorganisms on the order of two and three times those of the AC and ACC culture media, respectively.
The MPN for the actinobacteria group was lower than the typical AC (Starch-Casein) and ACC-free (Starch-Free Casein) media. However, for the culture medium containing the chitosan biopolymer, there was a significant increase in the MPN, from which we inferred that the inclusion of the chitosan biopolymer caused an increase in the microbial community (Figure 3). In addition to being Gram-positive bacteria with high C + G contents (Ventura et al., 2007), actinobacteria are degraders of organic matter such as cellulose, lignin and chitin. They generate protein biomass or even serve as food for other organisms (Gava, Pereira, Fernandes, & Neves, 2002).

According to Sawaguchi et al. (2015), actinobacteria, which would be tolerant to chitosan, are involved in the initial process of chitosan degradation. The DNA bands corresponding to Kitasatospora, Streptomyces and the unclassified Ktedonobaceter bacterium disappeared on day 16, and other major bands emerged. The subsequent succession of the bacterial community structure remains to be elucidated.
As is illustrated in Figure 3, the increase in the number of microorganisms present in the ACQ culture medium suggests that the chitosan biopolymer acted as a substrate for the actinobacterial community. Another important characteristic of actinobacteria is the production of a set of extracellular enzymes, such as those with cellulolytic activity that act in the degradation of components of the plant cell wall, and secondary metabolites, which act directly or indirectly in the promotion of plant growth (Sousa, Soares, Garrido, & Lima, 2009).
Comparison of the three culture media
According to the American Standard for Testing and Methods (ASTM D883-00), biodegradable polymers are polymers whose degradation results primarily from the action of microorganisms. These organisms, found naturally in the soil, are commonly called the microbial community, and they are made up of varied populations, where ecological relationships are not easily characterized because the soil and the microbial community are heterogeneous and difficult to be sampled uniformly (Rocha et al., 2015). This is a common occurrence in the rhizosphere, a region of the soil where the greatest concentration of microbial organisms is found, depending on the availability of nutrients and the quality of the substrate.
Considering the culture media developed in the present work, where the energy source was replaced by a 2% (w v-1) chitosan biopolymer solution, it is evident that the soil contained microbial communities with a natural ability to degrade this polymer. Thus, the MPN method was found to be efficient for detecting microorganisms with a natural ability to degrade the chitosan biopolymer, and the degradation of the chitosan biopolymer could be verified using this method. However, there is a variation in the number of microorganisms with respect to changes in the environment, especially with the replacement of the carbon source by the chitosan biopolymer.
The means of the MPN for the medium containing the biopolymer chitosan were lower for the groups with fungi and bacteria than for the typical culture media. The comparative results did not show significant differences between the culture medium containing the chitosan biopolymer and the medium without dextrose.
The tests performed with the culture medium for actinobacteria showed that the substitution of the energy source by the insertion of the chitosan biopolymer at the concentration of 2% (w v-1) resulted in an increase of its population. Tests carried out with fungi and bacteria showed that the polymer was selective for growth of these microorganisms. There is a greater tendency for degradation of the chitosan biopolymer than the other groups, as is shown in Figure 3.
Thus, observations of the colonies were made after the cultivation of the isolates in culture medium, inoculation, and incubation for seven days in a B.O.D. at 28 ± 2ºC to obtain the initial assessment of the general morphological characteristics of the possible actinobacteria. At the end of this period, samples of isolates 1, 2, 3 and 23 were transplanted. Weekly observation was performed for 30 days.
As is shown in Figure 4, the photos of samples of isolates from ACQ culture medium [starch-casein culture medium, excluding starch and including the 2% (w v-1) chitosan biopolymer] were taken with a digital camera.
After the 30-day period, samples were taken from isolates 01, 02, 03 and 23, and analyses of the cell arrangements were performed. The structure and arrangement of the cells, supposedly actinobacterial, were observed under a Bioval optical microscope with a Canon Bel Photonic, 5,0 Megapixel digital camera, with 100X magnification.
After incubation, the slides were observed under a microscope using the techniques of bright field, phase contrast and interferential contrast. The images obtained were compared with those contained in the Guide for the Classification of Streptomycetes. According to Porsani, Kolm, & Pimentel, 2017; (apud Pridham, Hesseltine, & Benedict, 1958), the red, reddish pink and gray-blue colorations of Monoverticillus-Spira were compatible with GRAM strains, isolated from soil samples and grown in ACQ culture medium [starch-casein medium without starch and with 2% (w v-1) chitosan], as is shown in Figure 5 A01, A02, A03 and A23, possibly related to the genus Streptomyces.

Ghinet et al. (2010) isolated seven strains of Streptomyces from clay soil. These microorganisms were incubated with chitosan for 11 days. They concluded that a chitosan-hydrolyzing enzyme, called CsnA, produced by a chitosan degrader, was present. They also concluded that the enzyme is involved in protecting against the antibacterial effect of chitosan on the bacterium (Ghinet et al., 2010).
Several microorganisms, including bacteria, have been reported to efficiently produce chitosanases to degrade the chitosan biopolymer into glucosamine oligomers (Aam et al., 2010). In addition, fungi and actinomycetes also produce chitosan oligomers from chitosan. The oligomers of D-glucosamine (GlcN) and N-acetyl-D-glucosamine (GlcNAc) have interesting biological activities, including antitumor effects (Chiang et al., 2003; Barka et al., 2015, Park et al., 1999), hypocholesterolemic effects (Shimosaka, Kumehara, Zhang, Nogawa, & Okazaki, 1996), and antimicrobial activities (Wang, Chen, & Wang, 2008; El Ouakfaoui & Asselin, 1992).
Chitosanases are produced by many organisms, including actinomycetes, fungi, plants and bacteria (Pagnoncelli et al., 2010). Bacterial chitosanases have received special attention because they are important for the maintenance of an ecological balance, and they have been used to determine the mechanism of hydrolysis of chitosan. The characteristic properties of chitosanase, chito-oligosaccharides and their derivatives have attracted the interest of the food and pharmaceutical industries because they can be used as edible additives, agricultural immunity controls and many other possible applications, such as agents for liver disease, atherosclerosis and hypertension (Shimosaka et al., 1996). Yin, Du, and Zhang (2009) reported that low molecular weight and oligomeric chitosans bring health benefits, such as regulation of immunity, antitumoral activity, hepatic protection, reduction of blood lipids, and antidiabetic, antioxidant and anti-obesity activities.
Conclusion
Significant differences in the MPN of actinobacteria in relation to the other groups were observed. The method employed was effective in determining the degradability of the chitosan biopolymer by observing the development of microorganisms subjected to the decrease in the availability of an energy source. Considering that the biodegradation, when carried out by a microbial community present in the soil, is observed because of the development of microorganisms subjected to the reduced availability of energy sources, it can be inferred that there was greater evidence of an increase in the microbial community for culture media of the ACQ type. In general, clear regions observed around microbial colonies were formed in the experiments using the MPN method. This observation is a strong indication of biodegradation, which indicates the need for further studies on these microorganisms.
Acknowledgements
The authors would like to FAPEMIG; LMS-Soil Microbiology Laboratory (UFVJM) and GEPAEQ-Group of Studies and Research Applied to Chemical Engineering (UFVJM).
References
Aam, B.B., Heggset, E.B., Norberg, A.L., Sørlie, M., Vårum, K.M., & Eijsink, V.G. (2010). Produção de quito oligossacarídeos e suas possíveis aplicações na medicina. Marine Drugs, 8(5), 1482-1517. doi: 10.3390/md8051482
American Standard for Testingand Methods [ASTM]. (2000). Annual book of American Standard Testing Methods: ASTM D883-00. Philadelphia: ASTM.
Barka, E. A., Vatsa, P., Sanchez, L., Gaveau-Vaillant, N., Jacquard, C., Klenk, H. P., ... Van Wezeld, G.P. (2015). Taxonomy, physiology, and natural products of actinobacteria. Microbiology and Molecular Biology Reviews, 80(1), 1-43. doi:10.1128/mmbr.00019-15
Castro, H. F., Classen, A. T., Austin, E. E., Norby, R. J., & Schadt, C. W. (2010). Soil microbial community responses to multiple experimental climate, change drivers. Applied and Environmental Microbiology, 76(4), 999–1007. doi: 10.1128/AEM.02874-09
Chiang, C.-L., Chang, C.-T., & Sung, H-Y. (2003). Purification and properties of chitosanase from a mutant of Bacillus subtilis IMR-NK1. Enzyme and Microbial Technology, 32(2), 260-267. doi: 10.1016/S0141-0229(02)00275-2
Cinelli, M., Coles, S. R., & Kirwan, K. (2014). Analysis of the potentials of multi criteria decision analysis methods to conduct sustainability assessment. Ecological Indicators, 46, 138–148. doi: 10.1016/j.ecolind.2014.06.011
Coelho, N. S., Almeida, Y. M. B., & Vinhas, G. M. (2008). A biodegradabilidade da blenda de poli (β-Hidroxibutirato-co-Valerato) amido anfótero na presença de microrganismos. Polímeros, 18(3), 270-276. doi: 10.1590/S0104-14282008000300014
Dijkstra, F. A, Carrillo, Y., Pendall, E., & Morgan, J. A. (2013). Rhizosphere priming: a nutrient perspective. Frontiers in Microbiology, 4(216), 1-8. doi: 10.3389/fmicb.2013.00216
Drigo, B., Kowalchuk, G. A., & Van Veen, J. A. (2008). Climate change goes underground: effects of elevated atmospheric CO2 on microbial community structure and activities in the rhizosphere. Biology Fertility of Soils, 44(5), 667-679. doi: 10.1007/s00374-008-0277-3
El Ouakfaoui, S., & Asselin, A. (1992). Diversity of chitosanase activity in cucumber. Plant Science, 85(1) 33-41. doi: 10.1016/0168-9452(92)90091-Y
Empresa Brasileira de Pesquisa Agropecuária [EMBRAPA]. (1997). Manual de métodos de análise de solo (2a ed.). Rio de Janeiro, RJ: Embrapa.
Fechine, G. J. M. (2013). Polímeros biodegradáveis: tipos, mecanismos, normas e mercado mundial. São Paulo, SP: Scielo
Gava, C. A. T, Pereira, J. C., Fernandes, M. C., & Neves, M. C. P. (2002). Seleção de isolados de estreptomicetos para controle de Ralstonia solanacearum em tomateiro. Pesquisa Agropecuária Brasileira, 37(10), 1373-1380. doi: 10.1590/S0100-204X2002001000004
Ghinet, M. G., Roy, S., Laprade, D. P., Harvey, M. È. L., Morosoli, R., & Brzezinski, R. (2010). Chitosanase from Streptomyces coelicolor A3(2): biochemical properties and role in protection against antibacterial effect of chitosan. Biochemistry and Cell Biology, 88(6), 907–916. doi:10.1139/o10-109
Hammer, O., Harper, D. A. T., & Ryan, P. D. (2001). PAST: Paleontological statistics software package for education and data analysis. Paleontologia Electronica, 4(1), 9.
Heggset, E. B., Tuveng, T. R., Hoell, I. A., Liu, Z., Eijsink, V. G. H., & Varum, K. M. (2012). Mode of action of a family 75 chitosanase from Streptomyces avermitilis. Biomacromolecules, 13(6), 1733-1741. doi: 10.1021/bm201521h
Hungria, M., & Araújo, R. S. (1994). Manual de métodos empregados em estudos de microbiologia agrícola. Brasília, DF: Embrapa.
Jahnel, M. C., Cardoso, E. J. B. N., & Dias, C. T. S. (1999). Determinação do número mais provável de microrganismos do solo pelo método de plaqueamento por gotas. Revista Brasileira de Ciência do Solo, 23(3), 553-559. doi:10.1590/S0100-06831999000300008
Jones, G., Song, Y., Chung, S., & Masison, D. C. (2004). Propagation of Saccharomyces cerevisiae [PSI+] prion is impaired by factors that regulate Hsp70 substrate binding. Molecular and Cellular Biology, 24(9), 3928-3937. doi: 10.1128/MCB.24.9.3928–3937.2004
Martin, J. P. (1950). Use of acid, rose bengal and streptomycin in the plate method for estimating soil fungi. Soil Science, 69(3), 215-232.
Merino, C., Nannipieri, P., & Matus, F. J. (2015). Soil carbon controlled by plant, microorganism and mineralogy interactions. Journal of Soil Science and Plant Nutrition, 15(2), 321-332. doi: 10.4067/S0718-95162015005000030
Murphy, S. F., Writer, J. H., McCleskey, R. B., & Martin, D. A. (2015). The role of precipitation type, intensity, and spatial distribution in source water quality after wildfire. Environmental Research Letters, 10, 1–13. doi:10.1088/1748-9326/10/8/084007
Nicolau, P. B. (2014). Métodos em microbiologia ambiental. Lisboa, PT: Universidade Aberta.
Pagnoncelli, M. G. B., Araújo, N. K., Silva, N. M. P., Assis, C. F., Rodrigues, S., & Macedo, G. R. (2010). Chitosanase production by Paenibacillus ehimensis and its application for chitosan hydrolysis. Brazilian Arquives of Biology and Technology, 53, 6, 1461-1468. doi: 10.1590/S1516-89132010000600023
Park, J. K., Shimono, K., Ochiai, N., Kazutaka, S., Kurita, M., Ohta, Y., ... Kawamukai, M. (1999). Purification, characterization, and gene analysis of a chitosanase (ChoA) from Matsuebacter chitosanotabidus 3001. Journal of Bacteriology, 181(21), 6642–6649. doi: 10.1046/j.1432-1327.2000.01608.x
Porsani, M. V., Kolm, H. E., & Pimentel, I. C. (2017). First record of fungi and actinobacteria isolated from the marine sediment collected in the intertidal region from an island located in the south of Brazil. International Journal of Current Research and Academic Review, 5(2), 51-60. doi: 10.20546/ijcrar.2017.502.007
Pridham, T. G., Hesseltine, C. W., & Benedict, R. G. (1958). A guide for the classification of Streptomycetes according to selected groups. Applied Microbiology, 6(1), 52-79.
Rocha, R. C. D. S., Mazaro, S. M., Possenti, J. C., Freddo, A. R., Zorzzi, I. C., & Dalacosta, N. L. (2015) Quitosana na indução de resistência ao tombamento de plântulas de tomate causado por Rhizoctonia solani Kuhn. Scientia Agraria Paranaensis, 16(4), 430-435. doi: 10.18188/1983-1471/sap.v16n4p430-435
Saito, Y., Yamanushi, T., Oka, T., & Nakano, A. (1999). Identification of SEC12, SED4, truncated SEC16, and EKS1/HRD3 as multicopy suppressors of ts mutants of Sar1 GTPase. The Journal of Biochemistry, 125(1), 130-137. doi: 10.1093/oxfordjournals.jbchem.a022249
Sawaguchi, A., Ono, S., Oomura, M., Inami, K., Kumeta, Y., Honda, K., … Saito, A. (2015). Chitosan degradation and associated changes in bacterial community structures in two contrasting soils. Soil Science and Plant Nutrition, 61(3), 471-480. doi: 10.1080/00380768.2014.1003965
Schinner, F., Öhlinger, R., Kandeler, E., & Margesin, R. (1995). Methods in soil biology. Berlin, GE: Springer
Shimosaka, M., Kumehara, M., Zhang, X.-Y., Nogawa, M., & Okazaki, M. (1996). Cloning and characterization of a chitosanase gene from the plant pathogenic fungus Fusarium solani. Journal of Fermentation and Bioengineering, 82(5), 426-431. doi: 10.1016/S0922-338X(97)86977-2
Sousa, C. S., Soares, A. C. F., Garrido, M. S., & Lima, F. S. (2009). Estreptomicetos no controle de Scutellonema bradys em túberas de inhame. Revista Ciência Agronômica, 40(4), 486-491.
Ventura, M., Canchaya, C., Tauch, A., Chandra, G., Fitzgerald, G. F., Chater, K. F., & Van Sinderen, D. (2007). Genomics of Actinobacteria: tracing the evolutionary history of an ancient phylum. Microbiology and Molecular Biology Reviews, 71(3), 495–548. doi: 10.1128/mmbr.00005-07
Wang, S.-L., Chen, S.-J., & Wang, C.-L. (2008). Purification and characterization of chitinases and chitosanases from a new species strain Pseudomonas sp. TKU015 using shrimp shells as a substrate. Carbohydrate Research, 343(7) 1171–1179. doi: 10.1016/j.carres.2008.03.018
Wieczorek, A. S., Hetz, S. A., & Kolb, S. (2014). Microbial responses to chitin and chitosan in oxic and anoxic agricultural soil slurries. Biogeosciences, 11, 3339–3352. doi: 10.5194/bg-11-3339-2014
Yin, H., Du, Y. & Zhang, J. (2009). Low molecular weight and oligomeric chitosans and their bioactivities. Current Topics in Medicinal Chemistry, 9(16), 1546-1559. doi: 10.2174/156802609789909795
Notas de autor